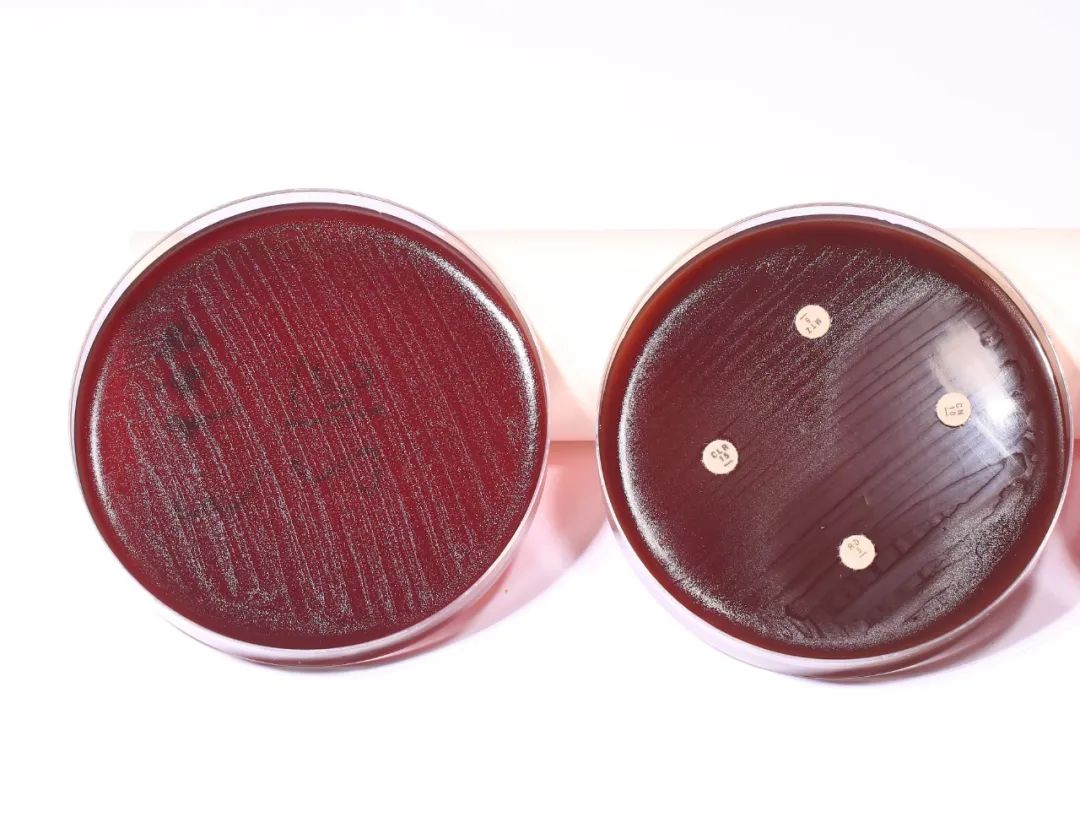

7亿人感染幽门螺杆菌,为什么好好吃药却有时杀不死它?
原创 深呼吸编辑部 39深呼吸

幽门螺杆菌检测越发受到重视,被职场打工人放进了每年必检项目的清单里。
33岁的燕子突然接到体检机构的电话,工作人员告知:她的13C呼气试验结果超标,有幽门螺杆菌感染,建议去医院治疗。这一番对话,被不知何时站在她身后的婆婆听到了。
作为常见的消化道致病细菌,幽门螺杆菌(英文简称Hp)的危害一直被医学界关注。它可寄生在胃黏膜组织中,长期感染后会引起慢性胃炎、消化性溃疡等疾病。更为严重的是,幽门螺杆菌已被世界卫生组织列为1类致癌物,80%的胃癌的发生都与它有关。
燕子的婆婆,退休前是某单位的卫生保健员,有洁癖的她非常担心儿媳妇会把幽门螺杆菌传染给儿子。“你刚才喝水有没有碰我儿子的杯子?”、“刷牙是不是共用漱口盅?”、“吃饭也得专碗专筷”,婆婆一天到晚紧张兮兮盯着燕子的一举一动。
这种过度干涉让燕子直呼“受不了”,她下定决心要清除体内的幽门螺杆菌。
01
7亿人感染!杀灭幽门螺杆菌“易也难”
数据显示,中国人群的幽门螺杆菌高染率高达50-60%, 意味着至少7亿人被感染,且以家庭聚集感染为特点。杀菌治疗在临床广泛展开,但是我国幽门螺杆菌呈现“三高一低”的特点,即高感染率、高致病力、高耐药率和低根除率,抗生素耐药是医生们尤其头痛的问题。
病人明明遵医嘱好好吃药了,为什么幽门螺杆菌杀不死?也不少人根除后再次感染,检查结果在“阴阳”之间打转。

◎ 从佛山过来的胃炎患者,幽门螺杆菌感染复发,贾林提醒她带上先生一起做根除治疗。/ 图:作者摄
广州市第一人民医院消化内科,是广东唯一的幽门螺杆菌规范化诊治门诊全国示范中心,每天接诊到来自各地的病人。
该中心主任医师贾林教授表示,根据国际指南,除非是年龄太大,或伴发严重疾病和脏器衰竭等抗衡因素,否则所有幽门螺杆菌感染者应该接受根除治疗,以减少胃炎、消化性溃疡及降低胃癌的风险。
贾林称,“幽门螺杆菌很狡猾,一开始比较容易根除,两联疗法就可以,但后来不断‘做加法’,联用2个药、3个药甚至4个药都根除不了,就是因为细菌对抗生素耐药了。”
这些年,贾林见到过太多的难治性幽门螺杆菌感染者,很多都经历了多次杀菌失败。病人眉头紧皱,焦虑不安,把“除菌”的最后希望寄托于眼前这位岭南名医。

◎ 寻找根除失败的原因,必须仔细研究病人的检查资料和病史。/ 图:作者摄
每当这个时候,贾林需要像警察破案一样,剖析原治疗方案,火眼金睛透过验单数据、用药记录、复查记录寻找失败的根源,然后修正治疗方案,对症下药补救“除菌”。
他强调,“根除幽门螺杆菌,医生不能盲目经验治疗,所有患者千篇一律使用一方一药,而难治性患者应该做个性化精准治疗,提取细菌做培养进行药敏试验,根据药敏数据为患者匹配适合的药物。”
02
那些根除失败的感染者,在他手里成功“除菌”
这天上午,贾林如往常一样在门诊忙碌着,病人络绎不绝。在候诊区,90后妈妈张梓琳不时起身向7号诊室张望,生怕过号了。

◎贾林在出诊中。/ 图:作者摄
她是在公司体检后发现感染了细菌,“我平时都是自己做饭,很少下馆子,也没有胃痛、反酸,以为自己很健康,没想到感染了幽门螺杆菌。”她不知道,早期感染幽门螺杆菌,其实大多数人都没有明显症状。
让张梓琳更意外的是,接受了两次杀菌治疗都失败了,她担心随着病情恶化会导致胃癌,从网上了解到广州市第一人民医院贾林医生开展幽门螺杆菌的精准根除治疗,赶紧抢号过来看诊。
其病历记录显示:第一次外院治疗是 2020年9月1日开始,使用四联疗法(奥美拉唑、阿莫西林、呋喃唑酮、铋剂),服药两周后13C呼气试验阳性。第二次治疗是在2022年7月,改用三联疗法(奥美拉唑、阿莫西林、铋剂)仍未成功。今年6月复查呼气试验结果高达19.8(正常值范围为0-4)。
贾林接诊后,给她做了胃镜检查,证实有幽门螺杆菌感染和胃炎。同时进行Hp药敏培养,提示她胃里的细菌对甲硝唑和左氧氟沙星都耐药。

◎体检呼气试验查出幽门螺杆菌感染,有必要进一步做胃镜检查。/ 图:蔡琦麟摄
“她没有用这两个抗生素,按理能成功,但为什么不行?”贾林沉思了一会,很快把目标锁定在抑酸药身上,“可能患者的肝酶CYP2C19(一种人体重要的药物代谢酶)基因多态性为快代谢型,而奥美拉唑是第一代抑酸药会很快被它代谢掉,影响抑酸作用的发挥和降低抗生素的杀菌作用。”于是,他果断把奥美拉唑替换成新型抑酸药。
果不其然,张梓琳连续两周服药,停药4周后复查13C呼气试验为3.67,困扰她多年的幽门螺杆菌终于远离了。

◎进行13C呼气试验,用力吹一口即可。/ 图:作者摄
贾林总结说,病人前两次除菌失败是因为治疗不规范:1、两次采用奥美拉唑根除,是第一代抑酸药。2、补救疗法没有采用Hp药敏-精准根除,反而降为三联。3、抑酸药的选择没有考虑患者肝酶CYP2C19基因多态性和采用新一代抑酸药PPIs(质子泵抑制剂)和P-CAB(钾离子竞争性酸阻滞剂)。
与张梓琳没有症状不同,63岁谭阿姨经常上腹不舒服,腹胀、反酸、嗳气、口臭统统都有,胃镜查出慢性糜烂性胃炎、幽门螺杆菌感染,两年前曾做过结肠癌手术。让医生意外的是,老人的Hp培养显示敏感菌,也就是对现有的抗生素都敏感。
“老太太的依从性很好,按时吃药和复查,使用潘妥洛克+左氧氟沙星+克拉霉素+铋剂四联疗法居然失败了。”这是从其他医生手里转过来的病人,贾林细看谭阿姨的病历和检查结果,逐一分析很快找到了原因。
“当第一次根除失败后,第二次作为补救治疗不能太早,要求间隔6个月,而且补救应避免使用同样的抗生素,这是基本原则。”贾林表示,针对谭阿姨的情况,应该还是肝酶基因多态性为快代谢型问题,制定出个性化补救治疗方案,如期除菌成功。

◎幽门螺杆菌分离培养-药敏检测室,助力Hp精准根除治疗。/ 图:医生提供
“医生一定要注意,幽门螺杆菌并非做药敏培养,就一定能根除成功。” 贾林指出,除了细菌抗生素耐药外,疗效还受到多种因素的影响,比如患者的肝酶,医生选择的药物。
目前而言,病人的肝酶因素是很多消化内科医生容易忽视的问题,往往只关注到细菌,导致根除失败。
早在2005年,广州市一医院一项发表在中华消化杂志的研究显示,中国人肝酶CYP2C19基因型分布,33.123%属于快代谢型EM,13.75%是慢代谢PM,59.38%是中间代谢IM。因此对于肝酶强的CYP2C19基因快代谢型病人不宜使用第一代抑酸药,必须新型PPIs或P-CAB才行。
03
幽门螺杆菌根除,避免用阿莫西林维酸钾
一连看了好几个病人,贾林发现根除失败都是抗生素出了问题,不约而同使用了阿莫西林克拉维酸钾片。他不由地皱起眉头,摇头说,“不对,不对,不能这么用!”
阿莫西林克拉维酸钾片是一个新药,零售价为十几二十块钱,比同样规格的阿莫西林要贵。根据克拉维酸药理机制,细菌产生β-内酰胺酶是β-内酰胺酶抗生素耐药的主要机制,克拉维酸是第一个应用于临床的β-内酰胺酶抑制剂。
而幽门螺杆菌对阿莫西林耐药,是由于与青霉素结合蛋白(PBPs)变异或孔蛋白改变引起膜通透性降低有关。与β-内酰胺酶产生无关,这是因为幽门螺杆菌耐药株中并不能检出β-内酰胺酶活性。
“加用克拉维酸钾并不能增强阿莫西林杀菌效果和提高根除疗效,反而会使治疗方案更加复杂,增加胃肠道反应、肝损伤、Stevens-Johnson综合征等不良反应,还增加了费用负担。”贾林表示,幽门螺杆菌根除应避免选用与克拉维酸的复合制剂,这应该引起所有医生和患者的重视。
作为一种致病细菌, 幽门螺杆菌的治疗需要用到抗生素,然而我国长期存在抗生素滥用严重,导致细菌耐药问题突出。贾林意识到开展幽门螺杆菌抗生素耐药的检测的必要性。
◎ 左:HP分离培养,右:HP抗生素药敏分析。/ 图:医生提供
全国各个地区的耐药情况不同,为了让病人得到有效的治疗,他带着团队脚踏实地把广州地区摸查清楚,研究统计了2005例幽门螺杆菌感染病例的抗生素的耐药情况。
截至2024年8月8日,监测显示:广州甲硝唑耐药率高达95.32%,左氧氟沙星耐药率32.01%,克拉霉素耐药率23.71%,利福平耐药率5.06%,庆大霉素耐药率0.94%,呋喃唑酮耐药率0.61%,阿莫西林耐药率0.28%,四环素耐药率0.06%。
“这就提醒我们医生不能再给病人使用甲硝唑了!”他强调。
对于走进诊室的每个幽门螺杆菌患者,贾林都会准备一张打印好的“Hp根除治疗须知”,与患者面对面详细讲解治疗方案,叮嘱注意事项和复查时机,然后让病人带回家。

◎ 幽门螺杆菌根除治疗须知。/ 图:作者摄
看诊完毕,他还会将Hp阳性病人拉进“无幽群”进行随访。
“我发现广州病人有一个很不好的习惯,遇到感冒或来月经的时候就不吃药了,殊不知会影响Hp根除疗效。”贾林说,“无幽群”让幽门螺杆菌诊疗和患者答疑形成闭环,方便医患联系,可以很好地提高患者用药的依从性,提高根除率。

◎ 建立“无幽群”为病人进行答疑随访。/ 图:作者摄
文章开头提到的燕子,她来到贾林门诊要求做幽门螺杆根除治疗,但其实她的13C呼气试验结果仅为 5.7,刚好是临界值(4-6)的范围,另外血清学抗体检测阳性。
“但抗体阳性并不能说明问题,”贾林谨慎表示,燕子需要做Hp培养试验,这是幽门螺杆菌感染诊断的金标准,如果呼气检测仪器未按要求每个月及时校正,也会影响检测的准确性。最终她的快速尿素酶试验阴性和Hp培养也无菌,所以目前不需要吃药。
不久前,贾林遇到一位病人曾在同一家医院根除失败5次、呼气试验总共做了13次。“医生,我的幽门螺杆菌总杀不死,是不是变成超级细菌了,没得治了?”病人愁眉苦脸地问到。
“不要着急,我看看先,”贾林仔细梳理病人三年半所有的处方和验单记录,发现诊断治疗存在许多问题,除抗生素抑酸药选择不当、根除疗法不规范、补救时机不对,还涉及Hp根除指征、临界值根除问题、呼气检测仪器未及时校正、Hp药敏和其他Hp检测试剂等质控问题。
“13次呼气试验阳性中有2次处于临界值,后来又飙升到31.7,以为复燃了。”贾林说,最后在广州市一医院行胃镜提示病人确实有慢性胃炎,但快速尿素酶Hp阴性,Hp培养也是阴性,说明病人根本没有细菌。后来的13C呼气试验结果1.4,再次验证贾林的判断。
“你已经没有幽门螺杆菌了,放一百个心吧。”贾林的话斩钉截铁,病人心头的大石终于可以放下,笑着走出诊室。
望着病人的背影,贾林感到肩上责任沉甸甸的。幽门螺杆菌的根除率之所以下降,既有病人的原因,也有医生原因,还有细菌的原因。

◎ 经常有汕尾、广西、新疆等地的病人慕名而来。/ 图:作者摄
据悉,由他主导的“幽门螺杆菌分离培养及精准根除新技术”获2024年度广东省卫生健康适宜推广技术,目前正在广州各级医院开展 Hp诊治“质控+培训”新模式。
“我们已经进入了幽门螺旋杆菌耐药检测及精准根除的新时代。”贾林强调,根除疗效和Hp抗生素敏感性与患者肝酶CYP2C19基因多态性类型、依从性、生活习惯以及卫生环境等有关,建议消化科医生针对难治性Hp感染患者在胃镜检查开单时就要充分考虑,在胃镜检查中及时提取细菌标本进行Hp培养+药敏,并开展基于药敏(药物敏感度测定)的幽门螺杆菌个性化精准根除疗法。
“希望建立起区域药敏检测中心,开展院区之间和医联体之间临床/研究,让更多病人得到精准根除治疗。”这成为贾林退休前的最大心愿。
(应受访者要求,文中姓名除专家外均为化名)
作者|叶芳
排版|深深
通讯员|魏星
封面|作者摄
首图|锐景视觉

